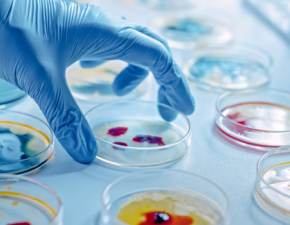

Reinkarnacja – czym jest?
Reinkarnacja to pogląd, zgodnie z którym dusza po śmierci ciała może odrodzić się na nowo, w innym ciele. To charakterystyczny element hinduizmu, a także wierzeń afrykańskich. Warto dodać, że chrześcijanie nie wierzą w reinkarnację, ponieważ jest ona sprzeczna z naukami obecnymi w tej religii. Temat reinkarnacji został podjęty przez psychiatrów, a także zaczął zastanawiać samych rodziców dzieci, które zaczęły opowiadać tajemnicze historie o tym, kim były kiedyś...
Badania dr. Stevensona
Dr Ian Stevenson był kierownikiem katedry psychiatrii na Uniwersytecie w Wirginii. Od 1961 roku badał dzieci, które miały tendencję do opowiadania o swoich poprzednich wcieleniach. Zebrał on 2500 historii i zaczął sprawdzać ich wiarygodność. Aż 1567 przypadków zostało zweryfikowanych i potwierdzonych – okazało się, że dzieci opowiadały o osobach, które naprawdę żyły. Dzieci znały imiona tych osób oraz miejsca ich zamieszkania z ostatnich lat ich życia. Naukowiec uznał za mało prawdopodobne, aby dzieci mogły z taką dokładnością zmyślać te historie.
Przypadek dziewczynki ze Sri Lanki
Jeden z przypadków, który opisał dr Stevenson, dotyczył pewnej dziewczynki ze Sri Lanki. Pewnego dnia podsłuchała ona, jak mama wymawia nazwę miasta "Kataragama". Warto dodać, że dziecko nigdy wcześniej o tym mieście nie słyszało. Wtedy dziewczynka zaczęła opowiadać o tym, że utonęła w tym mieście po tym, jak jej brat wepchnął ją do rzeki. Powiedziała też, że miała ojca o imieniu Herath, który był łysy i sprzedawał kwiaty na targu. Mieszkali w domu, który był blisko świątyni, w której ludzie rozbijali o ziemię kokosy, a na podwórku przy domu mieli psy, które karmiono mięsem. Dr Stevenson zweryfikował tę opowieść. Okazało się, że w mieście Kataragama żył mężczyzna, który sprzedawał kwiaty na straganie, a którego córka utonęła podczas zabawy z bratem. Dom mężczyzny przylegał do świątyni, gdzie wierni odprawiali religijny rytuał rozbijania kokosów o ziemię. Miał on również dwa psy, którym sąsiedzi rzucali przez płot mięso. Dr odkrył jednak, że mężczyzna nie miał na imię Herath, a było to imię należące do innej osoby z jego rodziny. Nie był on również łysy. Mimo tego liczba szczegółów znanych przez dziewczynkę była niesamowita. Zwłaszcza, że jej rodzina nie ma żadnych powiązań z rodziną z Kataragamy. Jej przedstawiciele nigdy się nie spotkali i nigdy o sobie nie słyszeli.
Przypadków opisanych przez Stevensona jest znacznie więcej. Doktor zmarł w 2007 roku, jednak jego badania i prace są kontynuowane. Część badaczy zaczęła uważać reinkarnację nie za pogląd, ale za fakt...